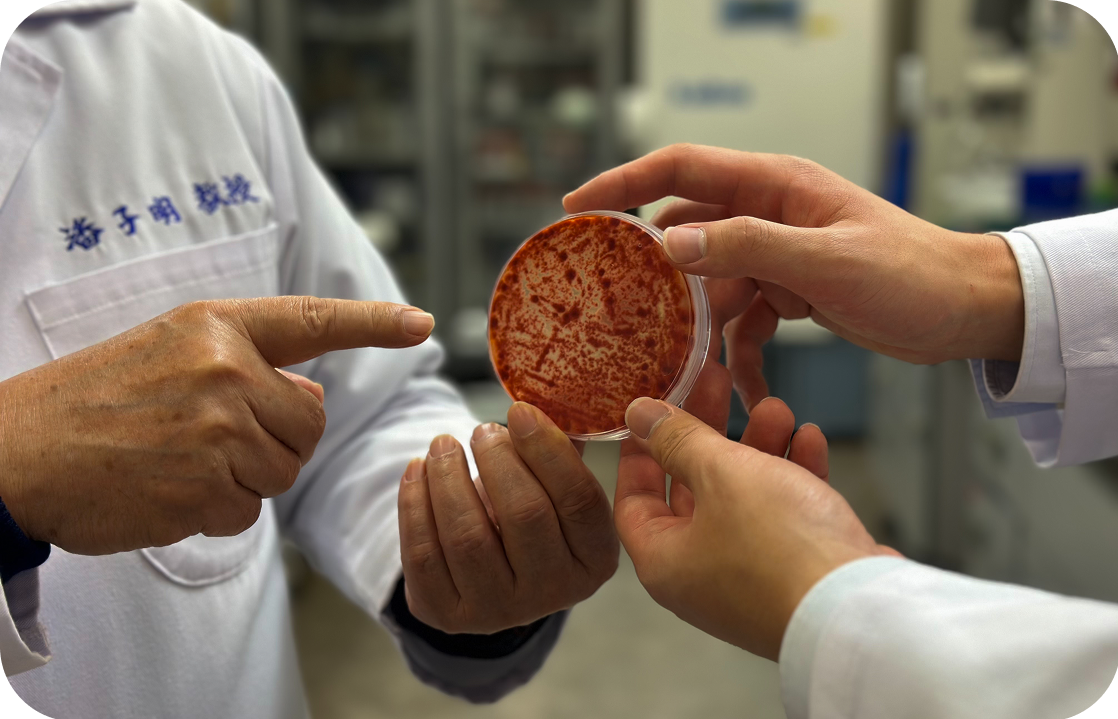

Our Mission
A Message From the Founders
It's Friday night. You're young, driven, and ready to make memories. But tomorrow demands your best. Do you go out and enjoy life, or stay in and protect your productivity?
This was the dilemma that my brother and I dealt with every single weekend, and our lives felt constricted. Until we realized: why not do both?
We created Drinkover to help people like us make memories while maintain momentum. Rooted in science, our mission is to empower high performers to live fully—no tradeoffs required.